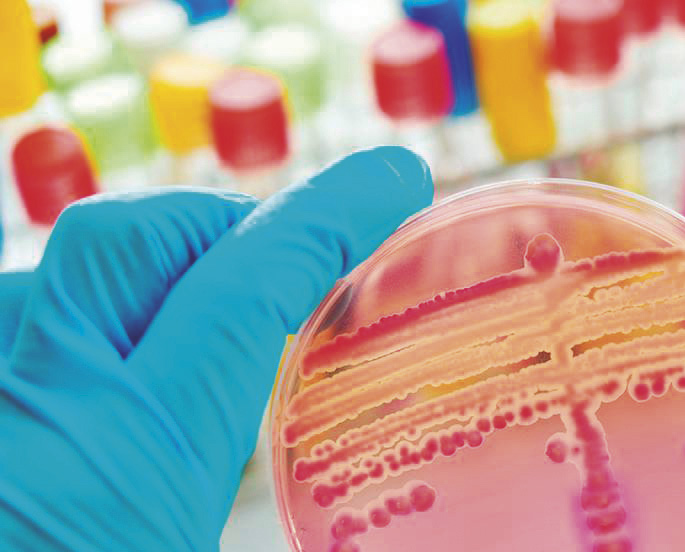

/Fuente: Federación Bioquímica de la Provincia de Buenos Aires /
PROCAL – Programa de Control de Alimentos
Se encuentran abiertas las inscripciones a los cursos virtuales del Programa de Control de Alimentos –PROCAL– de la Fundación Bioquímica Argentina que comienzan en marzo
Estos cursos virtuales se transmitirán a través de la plataforma zoom con la que cuenta PROCAL. Son cursos virtuales en tiempo real pero además todas las clases quedan grabadas para que los participantes puedan acceder a la plataforma de forma diferida para volver a ver y escuchar la presentación de los respectivos docentes.
Curso de Inspectoría bromatológica
Dirigido a: inspectores bromatológicos, directores de Bromatología, técnicos de laboratorios bromatológicos, jueces de falta.
Objetivos: capacitar al inspector/ a bromatológico municipal en métodos para la detección de alimentos que comprometan la salud de la población. Labrado de los diferentes tipos de actas de ejercitación con resolución de situaciones problemáticas habituales.
Se desarrollará en 8 clases. Inicio: 25 de marzo. Finalización: 20 de mayo (devolución de evaluación). Días: 25 de marzo; 01, 08, 15, 22, 29 de abril y 6, 12 y 20 de mayo.
Arancel: $45.000
Director: Dr. Héctor Pittaluga

Curso de Control Microbiológico de aguas
Dirigido a: Bioquímicos, Tecnólogos en alimentos, Ingenieros en alimentos, químicos, técnicos de laboratorios de ensayos
Objetivos: Capacitar a los profesionales en la realización de análisis microbiológicos y saneamiento de aguas provenientes de distintas fuentes.
Se desarrollará en 9 clases. Inicio: 19 de marzo. Finalización: 9 de mayo.
Días: 19, 26 de marzo; 3, 9, 16, 23 y 30 de abril; 7 y 9 de mayo.
Arancel: $ 60.000
Docente: Dr. Oscar López>

Curso de Microbiología de superficies vivas, inertes y aire en el ambiente en la industria de alimentos
Dirigido a: Estudiantes, Bioquímicos, Biólogos, Lic. en Química, Ingenieros en alimentos, personal técnico que se desempeñe en Laboratorios de control de calidad, supervisores de producción.
Objetivos: Obtener información de las condiciones higiénico/sanitarias de elaboración, detectar fallas en los procesos de limpieza, conocer los microorganismos presentes en el ambiente, aplicar medidas correctivas ante desvíos, reducir la probabilidad de reclamos y recall, asegurar la inocuidad del alimento. Se desarrollará en 6 clases del 31 de marzo al 5 de mayo.
Días: 31 de marzo; 7, 14, 21, 28 de abril y 5de mayo.
Docente: Bióloga Alina Del Mar Infante
Arancel: $ 45.000